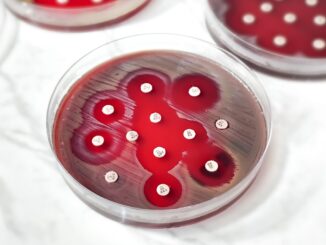

Month: November 2025

October 2025
October 2025

Designs

Designs

Designs

October 2025

Designs
Creating drought-resistant Brassica napus (canola) through bacteria-mediated RNA interference
Gabe Anoos, Mercy Awosoga, and Anna Billones, Catholic Central High School, Lethbridge, Alberta, Canada
Amira Bach, Jovin Bach, Aysha Al Khater, Dana Omar, and Raafae Rasool, Chinook High School, Lethbridge, Alberta, Canada
Elyse Burgess, Nicole Burgess, Charlotte Fink, Saachee Josan, Nora Laird, Agrim Paudel, Jacqueline Sadr, and Maya Walton, Lethbridge Collegiate Institute, Lethbridge, Alberta, Canada
Ian Benkoczi, Mazen Chemissany, Avinash Chowdhury, Amryn Mutti, Selina Sun, Jerry Wang, Kathleen Wu, and Bobby Zhao, Winston Churchill High School, Lethbridge, Alberta, Canada

Designs

Designs

Designs
